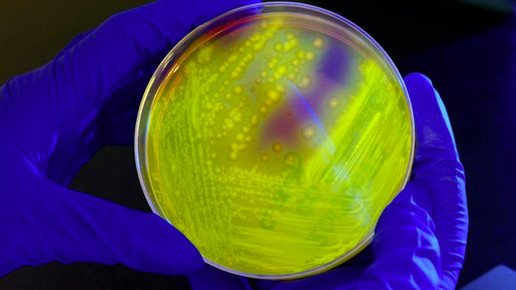

Problemkeim in Octenidol md Mundspüllösung
Octenidol md Mundspüllösung muss in allen Vertriebswegen zurück. Über den freiwilligen Rückruf aufgrund einer möglichen mikrobiellen Verunreinigung informiert MPC International S.A..
Das Medizinprodukt ist möglicherweise mit dem gramnegativen Bakterium Burkholderia cepacia verunreinigt. Der multiresistente Problemkeim ist im Grundwasser und feuchten Erdboden zu finden. Für gesunde Menschen stellt der Keim in der Regel keine Gefahr dar, jedoch kann eine Infektion für Mukoviszidose-Patienten lebensbedrohlich sein. Denn bei Menschen mit Zystischer Fibrose oder einer Immunschwäche kann Burkholderia cepacia zu Pneumonien oder einer schnellen Abnahme der Lungenfunktion führen, die tödlich sein kann.
Octenidol md Mundspüllösung muss in der Charge 1513962 zurück. Weitere Produktionsreihen seien nicht betroffen. Der freiwillige Rückruf richtet sich an Apotheker, Ärzte, Kliniken, Altenheime, Händler und Einkäufer. Diese sollen sicherstellen, dass „alle betroffenen Personen über diese Meldung informiert werden.“ Händler, die das Medizinprodukt in der betroffenen Charge weiterverkauft haben, werden gebeten, die Kunden zu ermitteln und über den Rückruf zu informieren.
Die Empfänger des Rückrufes werden außerdem gebeten, das Warenlager zu überprüfen und betroffene Ware unter Quarantäne zu stellen und sicherzustellen, dass die Lagerware der Charge 1513962 nicht verwendet wird. Warenbestände sollen mit dem dem Rückruf beigefügten Antwortformular retourniert werden.
Octenidol md Mundspüllösung wird von Schülke vertrieben. Es handelt sich um eine gebrauchsfertige Lösung zur Dekontamination des Mund- und Rachenraumes durch eine physikalische Reinigung. Die Mundspüllösung soll eine Multi-Resistente-Erreger (MRE)-Dekontamination erreichen. Außerdem kann das Medizinprodukt zur unterstützenden Wundbehandlung von Läsionen im Mundraum angewendet werden.
Anwender sollen zwei- bis dreimal täglich den Mund- und Rachenraum für etwa 30 Sekunden spülen. Anschließend wird die Lösung ausgespuckt. Dazu wird eine Menge von 10 bis 15 ml empfohlen. Das Medizinprodukt ist nicht für Säuglinge oder Kinder jünger als drei Jahre geeignet. Während der Therapie können reversible Geschmacksstörungen auftreten. Octenidol md Mundspüllösung sollte nicht in Kombination mit PVP-Jod angewendet werden, da dies zu einer Minderung der antiseptischen Wirkung des Jods führen kann.
2009 wurden verschiedene Präparate aufgrund einer Kontamination mit Burkholderia cepacia zurückgerufen. Betroffen waren damals Doreperol-Mundspray, Wick Sinex Naenspray und Paracetamol in den USA. Der jüngste Rückruf stammt aus dem September 2016.

APOTHEKE ADHOC Debatte